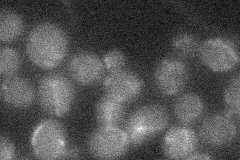
YIL120W

View description
Multidrug transporter of the major facilitator superfamily, required for resistance to quinidine, ketoconazole, fluconazole, and barban
Localization:
Intensity:
Fold change:
Significance:
-
C’ GFP library in SD

below threshold16.19 -
N' NOP1pr-GFP in SD

cell periphery,ER59.3728 -
N' TEF2pr-mCherry in SD

cell periphery,vacuole57.1939 -
N' NATIVEpr-GFP in SD
below threshold17.5535 -
N' TEF2pr-VC and Cyto-VN in SD

cytosol29.3143 -
C’ GFP library in SD+DTT

cytosol15.220.93No -
C’ GFP library in SD+H2O2

cytosol15.870.97No -
C’ GFP library in Starvation Media

cytosol16.931.04No -
C’ GFP library on the background of Pup2-DaMP

below threshold -
C’ GFP library on the background of CCT mutant

below threshold15.18930.937539No
